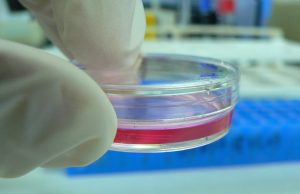
Study: Mice Exposed to Smoke In Utero Had Altered Sleep Patterns As Adults

Tag: Giovanna Zoccoli
Study: Mice Exposed to Smoke In Utero Had Altered Sleep Patterns...
Published in Scientific Reports, the study titled, “Early-life nicotine or cotinine exposure produces long-lasting sleep alterations and downregulation of hippocampal corticosteroid receptors in adult...